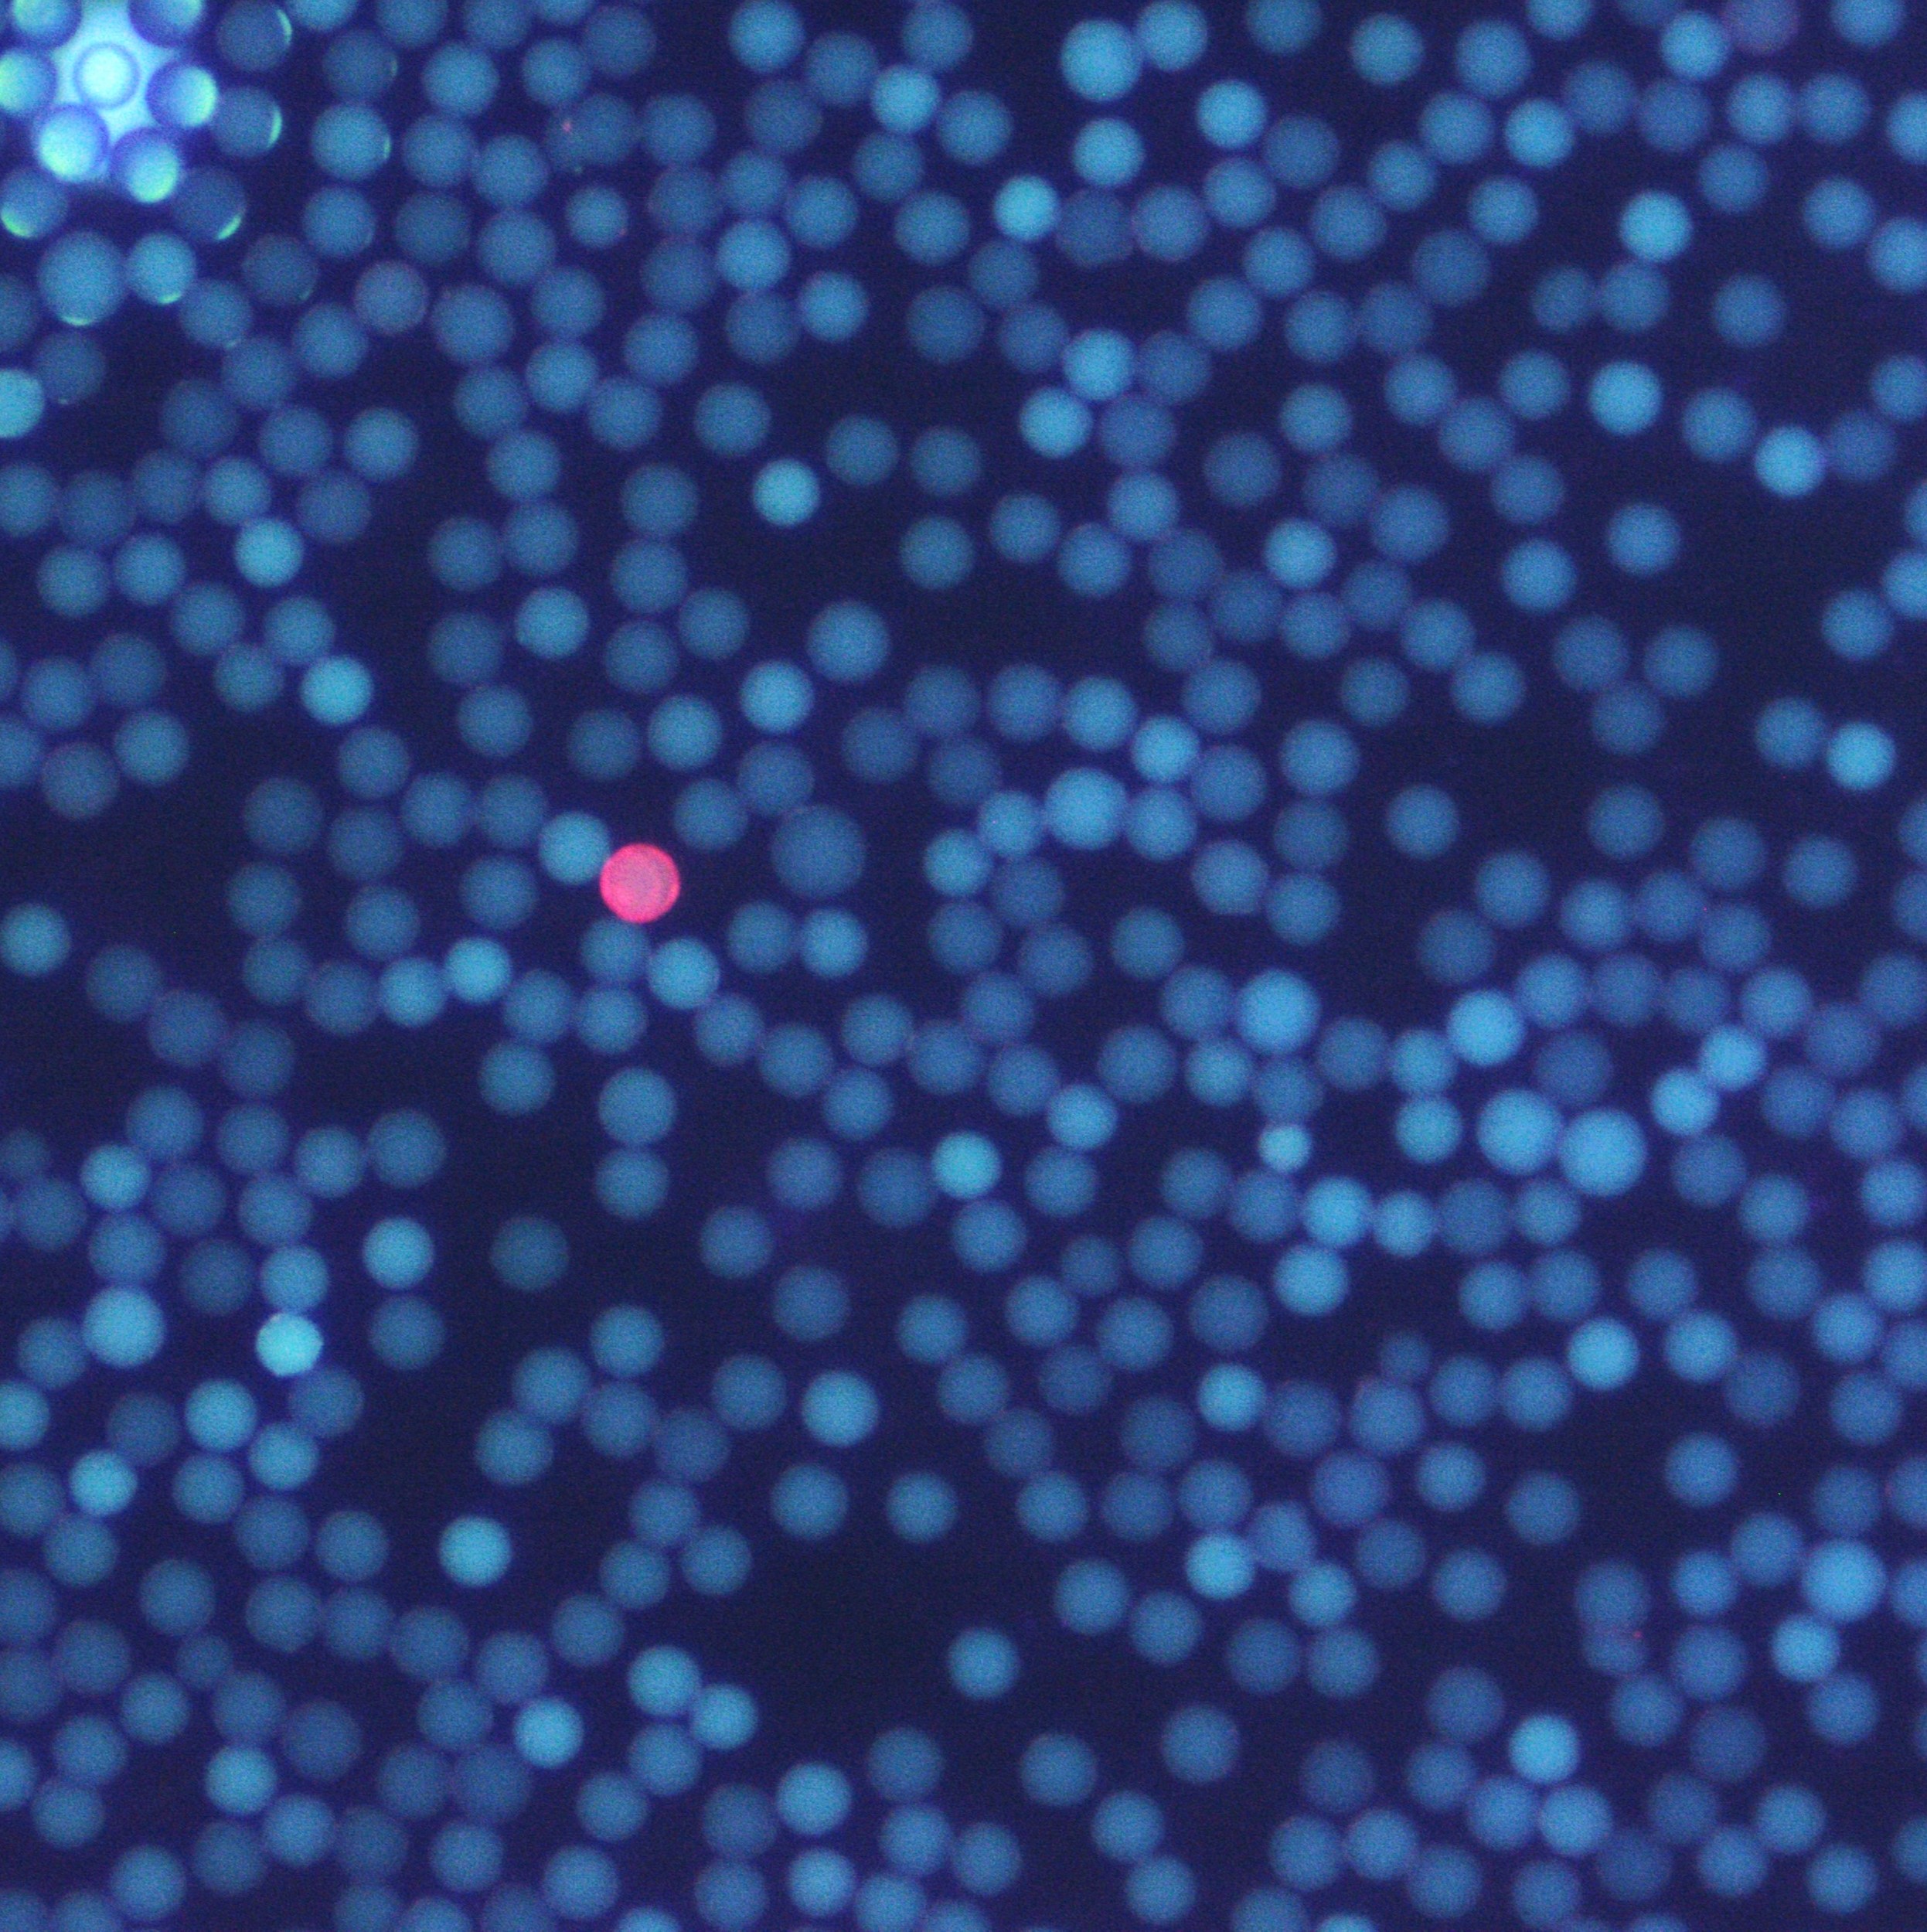
library beads

We are focused on the discovery of innovative treatments for the world's toughest diseases
Our Trilomer® platform of mirror-image cyclic peptides enables the targeted delivery of potent chemotherapy drugs for the treatment of cancer.
With traditional antibody-drug conjugates (ADCs), only a tiny fraction (<2%) of the injected dose binds to the tumor;
the remainer is slowly metabolized by normal tissues, causing the release of the potent chemotherapy drug or radioisotope, with toxicity to normal tissues and organs.
Peptides based on natural L-amino acids undergo recycling by renal scavenger receptors, also leading to more metabolism by normal cells.
Trilomer® mirror-image drug-conjugates overcome the liabilities of ADCs and peptide-drug conjugates by using 100% D-amino acids, which inherently possess high resistance to proteases (preventing premature release of chemotherapy drug) and also exhibit low uptake by renal scavenger receptors (reducing toxicity to healthy tissues and organs).
Trilomer® drug-conjugates rapidly penetrate tumors and bind specifically to cell-surface proteins on cancer cells, after which they are rapidly internalized, releasing the chemotherapy drug directly inside the cancer cell.
Due to their fully synthetic modular building blocks, affinity optimization and structure-activity relationships (SAR) can be performed much more rapidly than either traditional medicinal chemistry or targeted mutagenesis of monoclonal antibodies or biologics.

Can target any
cell-surface cancer protein
DNA-encoded library with
millions of D-peptides

Unimpeded renal clearance due to
100% D-amino acids
✦ targeted delivery of payloads: small size (<6 kDa for bivalent binder plus payload) allows for rapid tumor/tissue penetration
➥ optimized delivery vehicle for targeted radionuclide therapy or ADC-like chemotherapies
✦ low renal uptake: after tumor saturation, remaining drug conjugate rapidly cleared through kidneys
➥ 100% D-amino acid peptides are poorly recognized by renal scavenger receptors
✦ protease resistance: D-peptides are inherently resistant to proteases, heat/chemical denaturation
➥ no degradation in plasma or tumor microenvironment; payload only released upon internalization by cancer cell
✦ non-immunogenic: low probability of anti-drug antibodies
➥ inherent protease resistance prevents processing and display by antigen-presenting cells
✦ rapid internalization: reduced toxicity by preventing premature release of chemotherapy drug payload
➥ bivalent and/or biparatopic formats deliver payload intracellularly faster than monovalent formats
✦ clinically-validated targets: decreased clinical risk due to focus on known cancer-specific targets
➥ active preclinical development against established ADC targets, including HER2, cMET, DLL3, and PTK7.
Limitations of standard approaches:
⊗ traditional peptidomimetic libraries screened one compound at a time (slow to screen even with robotics)
⊗ DNA-encoded libraries (DELs) limited to fewer than 6 residues due to DNA degradation during chemical synthesis
⊗ phage/ribosome display techniques for peptidomimetics can incorporate relatively few non-natural amino acids
⊗ "mirror-image" phage display - very challenging to make synthetic D-amino acid protein target
⊗ display techniques have few methods for scaffold cyclization
Trilomer®; Discovery Platform advantages:
🗹 Trilo's DNA-encoded libraries allow for billions of drug candidates to be tested in a single tube
🗹 fully synthetic library technology is compatible with 10–15+ residues
🗹 agnostic to monomer choice; e.g., a library with 100% D-amino acids is straightforward
🗹 compatible with non-natural side chains and with beta-amino acids
🗹 library can be mono-, bi-, or tri-cyclized, including head-to-tail amide cyclization
• overview of mirror-image peptides:
"D-Peptide and D-Protein Technology: Recent Advances, Challenges, and Opportunities"
Chembiochem. 2023 Feb 14;24(4):e202200537. PMID: 36278392
• rapid tumor penetration:
"Whole-body PET tracking of a D-dodecapeptide and its radiotheranostic potential for PD-L1 overexpressing tumors"
Acta Pharm Sin B. 2022 Mar;12(3):1363-1376. PMID: 35530129
• see Figure 5 and Table S3 for superior tumor:kidney ratio
• reduced renal uptake:
"Bicyclic Peptides as a New Modality for Imaging and Targeting of Proteins Overexpressed by Tumors"
Cancer Res. 2019 Feb 15;79(4):841-852. PMID: 30606721
• see BCY-B4 vs BCY-B3 vs BCY-C4 in Figure S2 and Tables S5, S6, S11; 50-90% reduced renal uptake for D-peptide variant
• tumor targeting in humans:
"Preclinical and first-in-human evaluation of 18F-labeled D-peptide antagonist for PD-L1 status imaging with PET"
Eur J Nucl Med Mol Imaging. 2022 Nov;49(13):4312-4324. PMID: 35831714
• see Figures 7 & 8 for direct uptake od D-peptides in patients with lung or esophageal cancer

"Fast In / Fast Out" mechanism
increases tumor uptake and reduces toxicity

Peptides made from 100% D-amino acids
are poor substrates for renal scavenger receptors

Large binding surface allows targeting
to any cell-surface protein

Dr. Gish started his career in cancer research with scientist positions at Affymetrix and Eos Biotechnology, and later was Director of Biologics Technologies at PDL BioPharma and Research Fellow at AbbVie. With his expertise in target discovery and therapeutics development, Kurt has led ADCs from concept into multiple phase I human trials and is the inventor on 27 issued US patents.

Mr. Pujol, M.S., M.B.A., has over 30 years of business experience acquired in both Large Pharma (Sanofi, GSK) and in biotech smaller companies (Chiron, Maxygen, and Eos Biotechnology). He has extensive experience in commercial evaluations, business development, and corporate development. His last position at GSK was Group VP and Head of the product review at end of Phase II and Phase III.

Mr. Steinmiller has >20 years’ experience developing devices for biomedical research and diagnostics, resulting in 22 issued patents covering chemical synthesis, fluidics, and chemical analysis. He co-founded and raised venture financing for Claros Diagnostics which was acquired by OPKO Health, where he served as COO of OPKO Diagnostics.
Co-Founder
Chair, Scientific Advisory Board
Board of Directors
Strategic Advisor
Scientific Advisor
Scientific Advisor
Staff Scientist,
Chemical Biology
2019: Recipient of National Science Foundation grant for Small Business Innovation Research
2019: Recipient of Golden Ticket Award by AbbVie
2020: Recipient of Golden Ticket Award by Amgen
2023: Finalist for Golden Ticket Award by BMS
953 Indiana St, San Francisco, CA 94107
pierre@trilotx.com